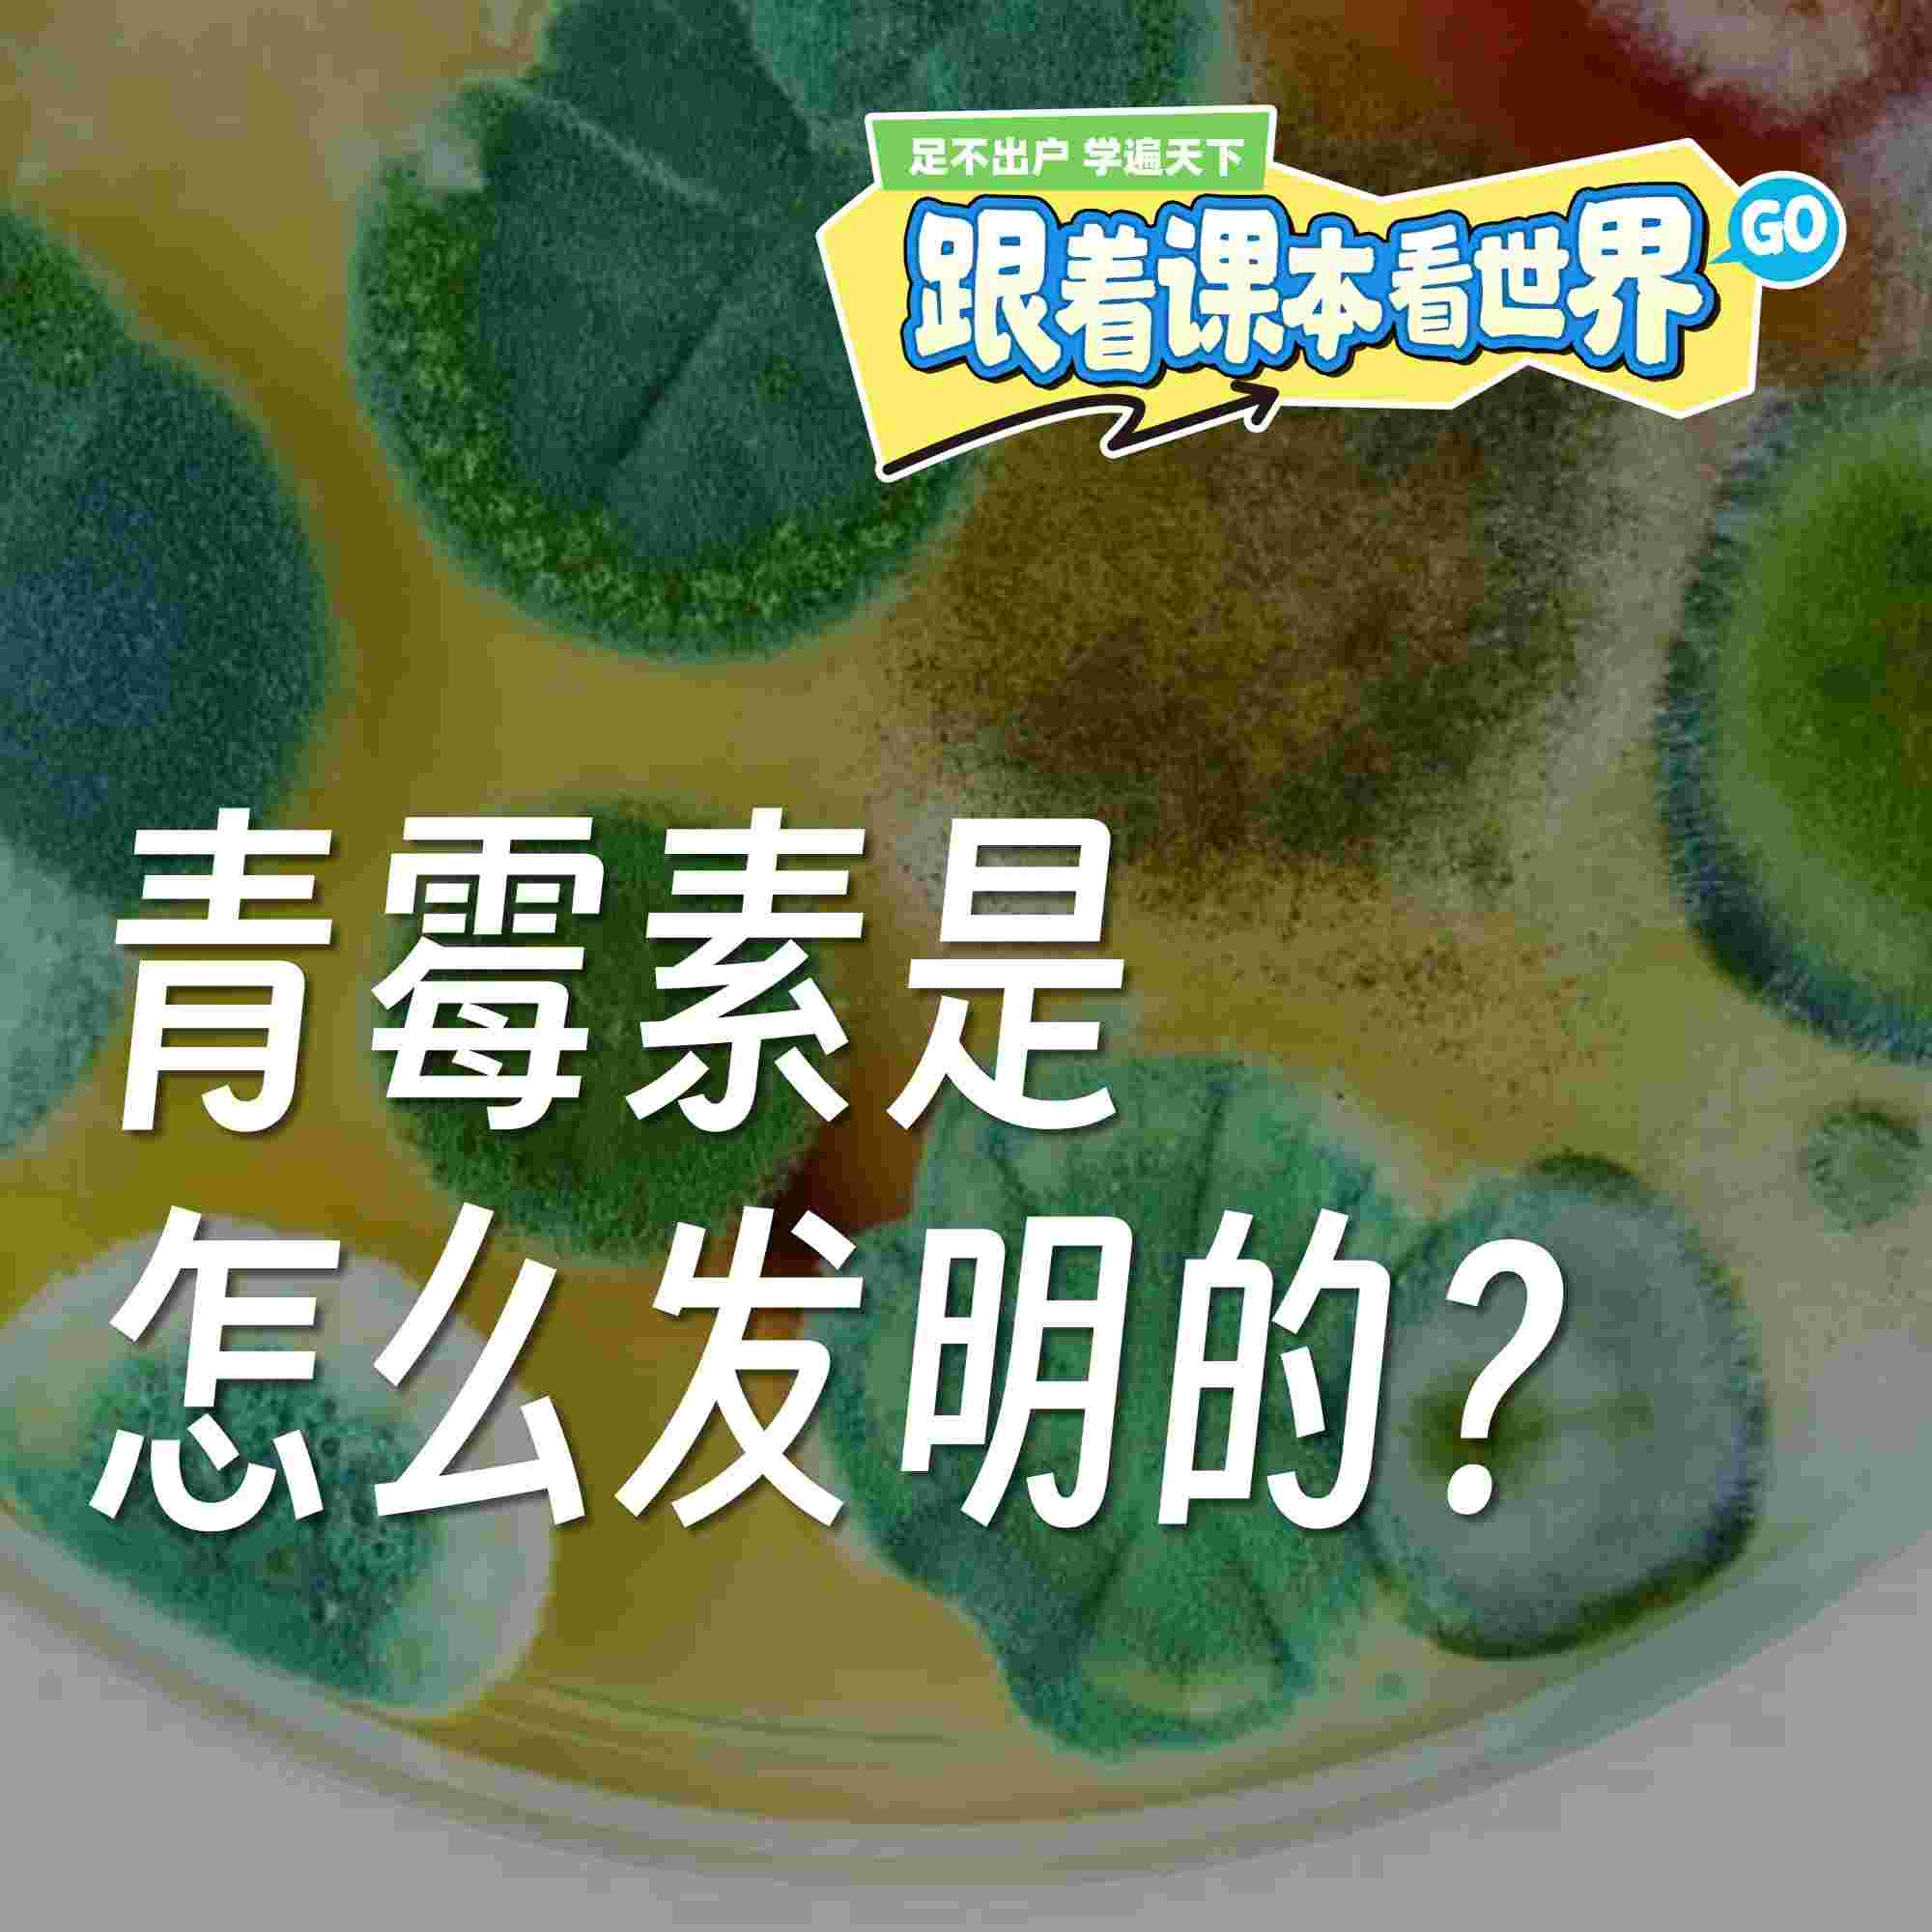
https://fdfs.xmcdn.com/storages/c0a5-audiofreehighqps/7F/23/GAqhfZkNFIfTAAol6wRHWRzQ.jpeg

孩子每天面对的课本,能不能变得更有趣?
知识,不只是书上的一行行文字,而是通往世界的一扇扇窗。
《跟着课本看世界》是一份给 6–12 岁孩子的声音周刊,每天 15 分钟,用结合课本知识的跨学科故事与时事热点,带孩子看懂世界、学会思考。
我们希望激发孩子的好奇心、观察力、思考力与表达力,陪伴孩子在真实世界中“看得见课本、用得上知识”。
我们为孩子设计了 3 档风格各异的栏目,每天换着听,样样都精彩:
好奇心树洞:
孩子的问题都有回应!我们收集孩子们的真实提问,认真研究、轻松讲解,用平视、真诚、不说教的方式回答孩子的发问。
新知剧团秀:
主播化身角色,戴上想象的帽子,把复杂的知识讲成一出出有趣的“小剧场”。让科学、历史、经济这些看起来“遥远”的知识,轻松走进孩子的日常。
环球新发现:
每周挑选一个孩子“能理解、有关联”的环球新闻,多角度分析其背后的议题,让孩子在探索世界的同时培养思辨能力,在广阔的世界中锻炼自己的心智。
适合对象:
对世界有好奇心的孩子及家长
早起后,吃饭时,睡觉前,推荐亲子一起收听,边听边聊
孩子每天面对的课本,能不能变得更有趣?
知识,不只是书上的一行行文字,而是通往世界的一扇扇窗。
《跟着课本看世界》是一份给 6–12 岁孩子的声音周刊,每天 15 分钟,用结合课本知识的跨学科故事与时事热点,带孩子看懂世界、学会思考。
我们希望激发孩子的好奇心、观察力、思考力与表达力,陪伴孩子在真实世界中“看得见课本、用得上知识”。
我们为孩子设计了 3 档风格各异的栏目,每天换着听,样样都精彩:
好奇心树洞:
孩子的问题都有回应!我们收集孩子们的真实提问,认真研究、轻松讲解,用平视、真诚、不说教的方式回答孩子的发问。
新知剧团秀:
主播化身角色,戴上想象的帽子,把复杂的知识讲成一出出有趣的“小剧场”。让科学、历史、经济这些看起来“遥远”的知识,轻松走进孩子的日常。
环球新发现:
每周挑选一个孩子“能理解、有关联”的环球新闻,多角度分析其背后的议题,让孩子在探索世界的同时培养思辨能力,在广阔的世界中锻炼自己的心智。
适合对象:
对世界有好奇心的孩子及家长
早起后,吃饭时,睡觉前,推荐亲子一起收听,边听边聊